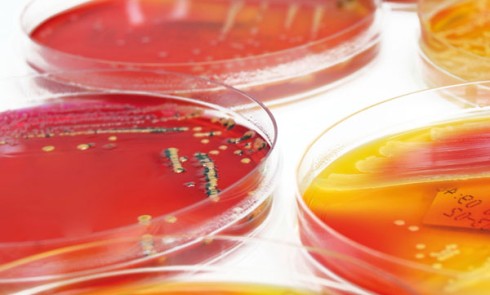

Formation
Intérêt des implants biseautés Osseospeed™ TX Profile®* dans la gestion des crêtes édentées
L’extraction d’une dent entraîne une modification importante des parois alvéolaires [1]. Ce remodelage est dissymétrique, bien souvent centripète, et aboutit...Deux lésions violacées de la lèvre inférieure
CAS 1 Motif de la consultation.Patient de 25 ans qui a consulté pour une lésion de la lèvre inférieure. Histoire...Des ultrasons au cabinet dentaire : pour quoi faire ?
Ces ondes de pression font vibrer le tympan qui se déplace de quelques millièmes à quelques centièmes de microns. Ces...La stérilisation en milieu hospitalier
Au niveau hospitalier, la stérilisation est une spécialisation de l’activité visant à la prévention des infections nosocomiales. Cent recommandations pour...Établir la bonne distance à proximité du patient
Dans une salle de cinéma, par exemple, la plus grande partie des places se remplissent toujours selon le même schéma...Exemple d’urgence La carie précoce de la petite enfance
Les dents sont affectées dans l’ordre chronologique de leur éruption, à l’exception des incisives mandibulaires qui, protégées par la langue...Restauration d’une dent dépulpée dans le secteur postérieur
La communication avec le laboratoire C’est une étape connue pour être importante dansla réussite d’une restauration prothétique. Ellea pour but...Les mini-implants pour patients âgés fragiles et précaires : alternative de choix ?
Dès aujourd’hui, la France en plein « papy-boom » doit relever le défi d’une population qui ne cesse d’augmenter en...Préservation du parodonte impacts innovants du tout céramique au numérique
Depuis de nombreuses années, les problèmes inhérents au couple parodonte-prothèse font débat et sont l’objet de multiples publications. In vitro...Les modèles de travail en prothèse fixée : dispositifs et conception
L’adaptation marginale d’un élément de prothèse scellée sur sa préparation constitue un objectif majeur d’intégration et de pérennité prothétique. Depuis...Les prothèses amovibles partielles métalliques sont-elles traumatisantes pour les dents supports ?
En raison de l’augmentation de l’espérance de vie, la proportion de la population partiellement édentée est plus importante (1). Plusieurs...Problématique du risque infectieux en prothèse : à propos de la chaîne prothétique
La problématique de la contamination de la chaîne prothétique demeure une préoccupation de santé publique. En effet, le risque infectieux...